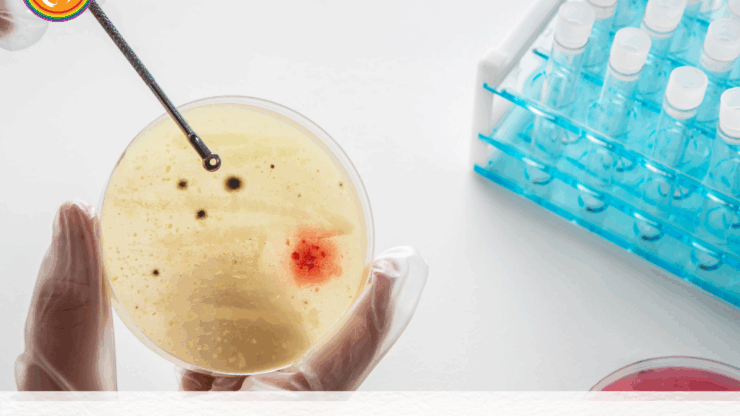
Age and Fertility: What to Expect at Every Stage of Life.

Understanding age and fertility can help individuals and couples make informed decisions about family planning. Fertility reaches its peak in the early 20s, when egg and sperm quality are highest, then gradually declines in the late 20s and early 30s. After 35, women may experience a sharper drop in ovarian reserve and embryo quality, while men may see decreased motility and…